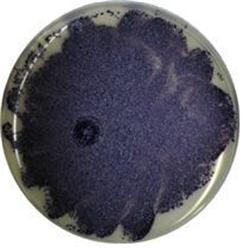

식의약용 등 산업적 활용 높고 비올라세인 대량 생산 기여
[화학신문 유혜리 기자]식품, 의약계 새바람을 불고 올 항암· 항균· 항산화 등의 기능성을 가진 색소 물질을 만드는 신종 미생물을 발견돼 업계가 주목하고 있다.
![]() |
| ▲ 신종 미생물 마실리아 EP15214 |
농촌진흥청(청장 정황근)은 우리나라 토양에서 청보라색의 색소 물질인 '비올라세인(Violacein)'을 생산하는 신종 미생물 '마실리아(Massilia) EP15214'를 발견하면서 대량으로 생산할 수 있는 조건을 확립했다고 10일 밝혔다.
비올라세인은 항암, 항균, 항산화, 항바이러스 등 다양한 의약적 기능이 보고되고 있을 뿐만 아니라 친환경 색소 화장품 및 식품 색소첨가제로 활용이 가능해 산업적으로 최근 많은 관심을 받고 있는 물질이다.
이번에 발견한 '마실리아 EP15214'는 영양 상태가 부족한 토양에서 생장하는 균주로 기존에 보고된 비올라세인 생산 균주들과 계통적으로 분리된 신종이다.
실험결과 25℃에서 최적의 성장을 보였으며 이 보다 높은 온도에서는 균의 성장이 억제되는 것을 확인했다.
![]() |
| ▲최적 비올라세인 생산조건 색소 생산량 |
농진청은 '마실리아 EP15214'에 대해 특허등록(등록번호 10-1549156)을 완료했고 비올라세인 합성 유전자에 대한 고유 지적 재산권도 획득할 예정이다.
농촌진흥청 생물소재공학과 이창묵 농업연구사는 "이번에 발견한 신종 미생물은 식·의약용 등 산업적 활용도가 높은 비올라세인을 대량 생산할 수 있는 국내 원천 소재로써 크게 기여할 수 있을 것으로 기대한다."고 말했다.
[저작권자ⓒ 화학신문. 무단전재-재배포 금지]